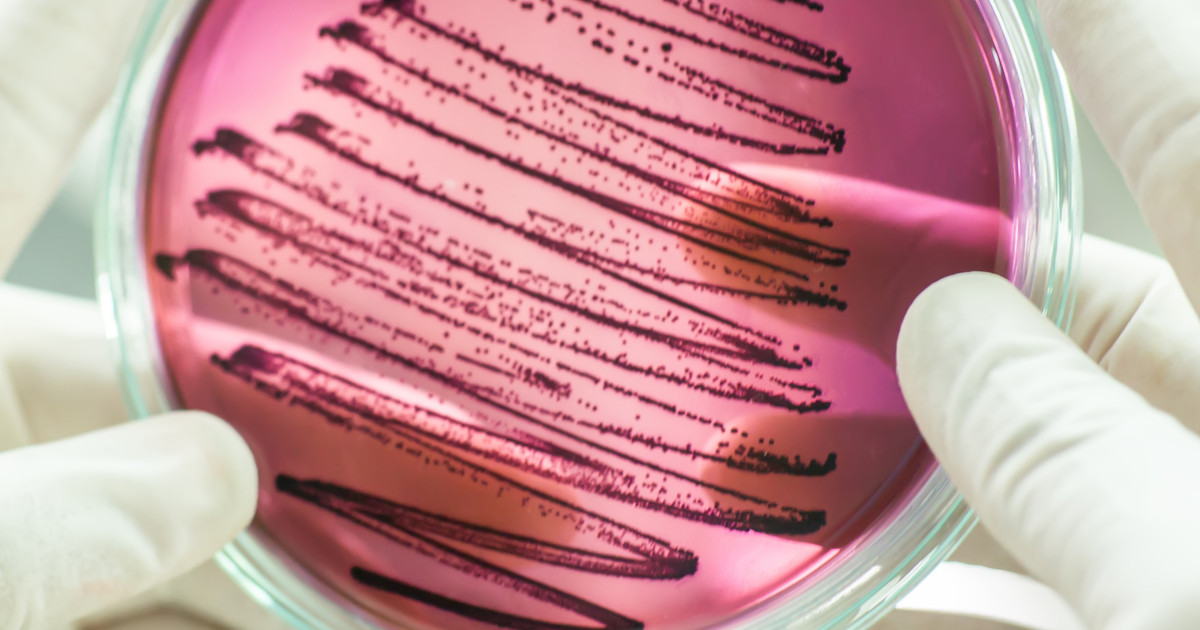

Understanding Rifampicin
Rifampicin, also called rifampin, is an antibiotic. It treats serious bacterial infections! It is available orally as well as intravenously. Active tuberculosis patients often take ten milligrams for every kilogram of their body weight daily! The maximum dose per day is six hundred milligrams. Most patients need this medication for six months! It is often used along with other medicines. Doctors must know about severe, persistent, or bothersome side effects.
This antibiotic is an effective tuberculosis treatment! However, patients also have other medications for tuberculosis available to them. This medication is also a strong endocarditis treatment. It is often used as a leprosy treatment as well! Of course, patients must understand how it works before they take it.
How It Works
Rifampicin is an antibiotic! In fact, it is an antimycobacterial medicine. Thus, this medication fights bacterial infections. It does so by preventing bacteria from finishing RNA synthesis! This antibiotic binds to the beta subunit of DNA-dependent RNA polymerase. This is what stops the RNA transcription process. The patient's liver absorbs this medication. When it is excreted, it is through feces!
It takes two to four hours for this medication to reach peak concentration. In healthy individuals, it has a half-life of three to four hours! However, it will stay longer in liver patients. The half-life in end-stage kidney disease patients is up to eleven hours.
Continue reading to reveal the uses for this medication next.
Uses

Rifampicin treats tuberculosis. It is often combined with other drugs for this purpose! Doctors prescribe it to prevent this condition as well. Of course, this antibiotic has other uses. It prevents meningitis in certain individuals. Specifically, this medication does it when patients have Neisseria meningitidis bacteria in their throat or nose! It stops patients from spreading this bacteria as well. However, it does not treat the symptoms of meningitis. Other conditions that this medication treats include leprosy and joint infections. It also helps with endocarditis!
Many patients take this medication for central nervous system infections. Two examples are brain abscesses and encephalitis! Doctors will also prescribe it 'off-label' for itching from liver disease. Some patients take it for brucellosis as well.
Discover the side effects of this antibiotic next.
Side Effects

Of course, rifampicin has several side effects! The common side effects include heartburn, headaches, and upset stomach. Women often experience menstrual cycle changes on this medication as well! Another side effect is a change to the color of a patient's sweat, urine, saliva, or tears. They will turn red, orange, or brown. Thankfully, this resolves once patients stop taking this antibiotic! Unfortunately, this medication often causes permanent tooth discoloration. Behavior and coordination changes happen as well. Some patients deal with appetite loss, pain in their abdomen, and diarrhea as side effects too!
This medication changes certain lab test results. Tests that it affects include red blood cell counts, serum uric acid levels, and liver function tests. Usually, it means lower red blood cell counts and elevated results in the other two! This medication causes liver disease in some patients. Thus, patients need to be aware of those warning signs! They include jaundice, dark urine, abdominal pain, and persistent nausea. Patients must tell their doctor about these signs immediately!
Get the details on precautions with this medication next.
Precautions

Patients must review their medical history with their doctor before taking this medication. They must do so because rifampicin is not safe for everyone. Examples of such patients include those who have a history of liver disease, diabetes, or bleeding disorders. Women often cannot take this medication in the last few weeks of pregnancy. The risk is bleeding in them and their baby! Breastfeeding women cannot take this antibiotic either. Patients must also use more than hormonal birth control while they are taking this medication. The reason is that it reduces the effectiveness of this method! Patients need to wear glasses instead of soft contact lenses due to the risk of staining.
This medication causes issues with drug screening tests. It makes the results inaccurate! Thus, patients must inform doctors that they are on this medication when they need such a test. Regular blood tests while taking this medication is a major recommendation. Tests check for infection! Patients usually continue this medication until their infection has cleared. They must take the oral form of this antibiotic without food. Taking it one hour before or two hours after a meal are both acceptable! Both cases require a full glass of water. As always, patients must take the full course. This prevents antibiotic resistance!
Reveal the medication interactions next.
Medication Interactions

Rifampicin interacts with over 490 other medications. Out of these, there are 198 major medication interactions! This is precisely why patients need to review their current medications with their doctor before taking this one. They also need to discuss the supplements that they take! Pharmacists are amazing for double-checking this list.
Certain interactions increase the risk of liver damage. Examples include mixing rifampicin with medications for cholesterol, blood pressure, and arthritis. Medicines that treat heart issues, seizures, and depression also increase this risk! Over-the-counter pain relievers also make the risk of liver damage higher. Rifampicin speeds up the body's removal of certain medications, including azole antifungals and oral diabetes medication. Calcium channel blockers and certain blood thinners are removed faster also. Patients must tell their doctor when they take these medicines! Adjusted doses are common. Other patients need to switch to other drugs.